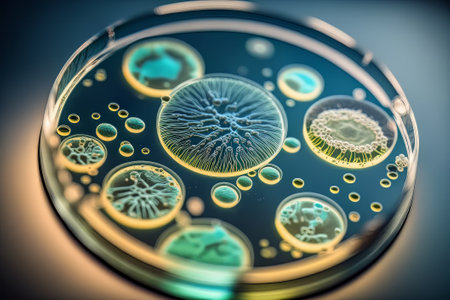
Bacteria and virus cells in a scientific laboratory. Created with Generative AI technologyの素材

素材 - Bacteria and virus cells in a scientific laboratory. Created with Generative AI technology
作品情報
Bacteria and virus cells in a scientific laboratory. Created with Generative AI technology
- ID:213247076
- 作品種別:
- 作者名:Volodymyr Konko
キーワード
- ai
- biochemistry
- biology
- biotechnology
- colours
- design
- disease
- dish
- epidemic
- experiment
- generative
- generative ai
- germ
- health
- illustration
- infection
- laboratory
- macro
- medicals
- medicine
- microbe
- microbiology
- microorganism
- microscopic
- mobile phone
- molecular
- organism
- petri
- research
- science
- scientific
- test
- virus
類似作品
Close-up of bac...
A close up of a...
Visualization o...
Red bacteria on...
High-resolution...
Close-up of pat...
High-res image ...
Blue bacteria w...
Germs under mag...
3d render of vi...
High-res image ...
Bacteria on a s...
Digital germs m...
Macro close up ...
Visualization o...
Surface with ba...
Microscopic Vie...
close-up of sci...
Conceptual imag...
Surface contami...
Digital illustr...
Detailed image ...
Bacteria and vi...
Bacteria are be...
Close-up of ger...
Digital model o...
High-definition...
Microscopic Vie...
Close-up of ger...
Laboratory petr...
Macro close up ...
High-resolution...
Close-up of ger...
Magnified view ...
High-definition...
Colorful bacter...
virus particles...
Close-up of a s...
close-up of bac...
Microscopic Vie...
Surface with ba...
Science and Lif...
Close-up of mic...